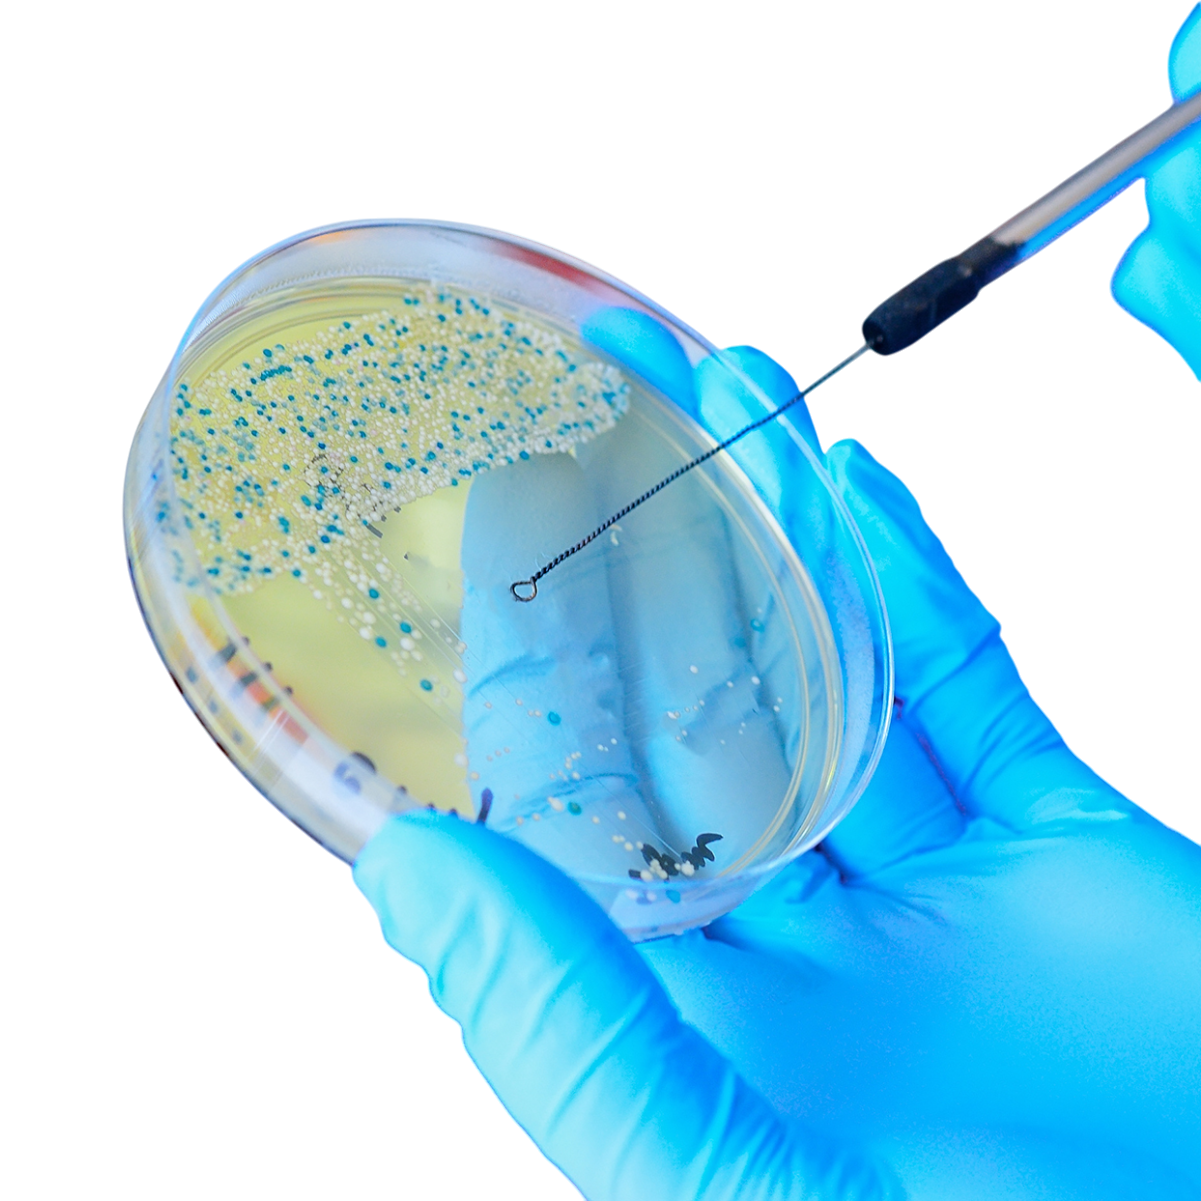

New Liver Extract
¥22,000
Unit price perProduct details
乾杯!お酒を飲むことが多い方の健康に!
【販売元】
TOKiS/東京電気株式会社
こんなお悩みの方に

お酒をよく飲む方
肝臓の負担を軽減し、健康的な毎日をサポートします。

疲れが取れにくいと感じる方
エネルギー生成を助ける成分が疲労回復をサポートします。

もっと元気が欲しい
活力成分が体を内側からサポートし、元気な毎日を応援します。

スッキリ目覚めたい方
肝臓をいたわる成分が夜間の代謝を助け、翌朝の寝起きを軽やかにします。
厳選した原料で毎日の健康をサポート
肝臓エキスとは
肝臓エキスサプリメントは、健康をサポートするために厳選された天然由来の肝臓エキスを使用し、肝臓の機能を助けることを目的とした栄養補助食品です。このエキスには、肝臓の健康を維持するために必要なビタミンやミネラル、アミノ酸が豊富に含まれており、体内の解毒作用を促進しながら疲労回復やエネルギー代謝をサポートします。特に、日々のストレスやアルコール摂取による肝臓への負担が気になる方や、健康的な生活を送りたい方におすすめで、活力ある毎日の土台作りに役立ちます。

香料・保存料・無添加の日本製
香料保存料無添加で国内で製造加工をしております。
日本国内のGMP認定工場にて厳しい品質管理の元製造を行っております。

厳選された肝臓サポート成分
新肝臓エキスには、マリアアザミやウコンエキス末、牡蠣エキス末、L-オルニチンなど、肝臓をいたわるために厳選された成分を贅沢に配合。
これらの成分が肝臓の解毒作用や健康維持をしっかりとサポートします。肝臓機能を強化することで、体全体の活力を引き出します。

現代の食生活に不足しがちな栄養素を補給
酢酸菌抽出物や亜鉛、タウリンなど、現代人に不足しがちな栄養素をバランスよく配合。これ1つで肝臓のケアだけでなく、全身の健康維持や代謝促進にも対応します。日々の栄養バランスをサポートしながら、内側から元気を届けます。

活力を引き出すパワフルな働き
エネルギー生成を助けるL-オルニチンやタウリンが含まれているため、疲労感を軽減し、体を内側から元気にします。疲れが取れないと感じる方や、忙しい毎日を乗り越えたい方に最適なサプリメントです。
厚生労働大臣登録検査機関検査済商品です
健康補助食品【試験番号】240517574-001-01
健康補助食品
【試験依頼先】厚生労働大臣登録検査機関一般財団法人食品分析開発SUNATEC放射線セシウム検査済
放射性セシウム検査済み
【試験成績書番号】240517574-002-01
【試験依頼先】厚生労働大臣登録検査機関一般財団法人分析開発期間センターSUNATEC
日本のGMP認定工場で製造を行っております
この商品は、GMP認定工場で厳格な品質管理のもと製造されています。原料の選定から製造工程、製品検査まで、すべての段階において高い品質基準をクリアしており、お客様に安心と安全をお届けします。
類似品にご注意ください
成分効果

L-オルニチン
L-オルニチンは、肝臓の解毒作用を助けるアミノ酸であり、体内でアンモニアの代謝を促進する働きがあります。この作用により、肝臓への負担を軽減し、正常な肝機能を維持することが期待されます。また、疲労回復やエネルギー生成をサポートする効果もあり、日々の健康を支えたい方や活動的な毎日を送りたい方に最適な成分です。

マリアアザミ
マリアアザミ(ミルクシスル)は、ヨーロッパを中心に古くから肝臓の健康を守るために用いられてきた伝統的なハーブで、その主要成分であるシリマリンは強力な抗酸化作用を持ち、肝細胞の修復や再生をサポートするとされています。特に、解毒作用を促進しながら肝臓に負担をかける有害物質から保護する働きが期待されており、疲労感の軽減やエネルギーの回復、体内環境の整備にも役立つことから、現代の健康維持において注目を集めています。

ウコンエキス末
ウコンエキス末は、主要成分であるクルクミンを豊富に含み、強力な抗酸化作用や抗炎症作用が期待される自然由来の成分です。このクルクミンは、肝臓の解毒機能をサポートし、有害物質の排出を促すことで肝細胞の健康を守る働きがあります。また、消化機能の促進や体内環境の改善にも寄与し、日々の健康維持に役立ちます。特にお酒を飲む機会が多い方にとっては、アルコールが肝臓に与える負担を軽減し、翌朝のスッキリとした目覚めをサポートする効果が期待できるため、健康的なライフスタイルを目指す方におすすめの成分です。
酢酸菌抽出物
酢酸菌抽出物は、腸内環境を整える力を持つ成分で、健康的な消化や栄養吸収を助ける効果が期待されています。腸内フローラを良好な状態に保つことで、体全体の健康を支える役割を果たします。さらに、免疫力の向上にも寄与するとされ、健康維持に欠かせないサポートを提供する成分です。

タウリン抽出物
タウリン抽出物は、肝臓をはじめとする内臓の働きを助ける重要な成分であり、エネルギー代謝や疲労回復を促進する効果が期待されています。ストレスや疲れが溜まりがちな現代人にとって、活力を取り戻すために役立つ成分です。また、循環器系の健康をサポートする働きもあるため、全身のバランスを整えたい方におすすめです。

瀬戸内海産牡蠣エキス末
牡蠣エキスは、自然由来の栄養素を豊富に含み、肝臓の機能をサポートするほか、免疫力の向上にも役立つ成分です。特に亜鉛やタウリン、アミノ酸が豊富で、健康維持に必要な栄養素を効率よく摂取できます。牡蠣の持つ滋養強壮作用は古くから知られており、疲労回復やスタミナ向上を求める方に適した天然素材です。

亜鉛
亜鉛は、酵素の働きをサポートする必須ミネラルであり、肝臓の代謝を助けながら、体の免疫力を強化する重要な役割を担います。また、細胞の生成や修復を促進する効果があり、肌や髪の健康を維持する上でも欠かせない栄養素です。特に現代人には不足しがちな成分の一つで、健康全般を支えるための重要なミネラルと言えます。
※画像はイメージです。
ご注意点
New Liver Extract
¥22,000
Unit price per乾杯!お酒を飲むことが多い方の健康に!
【販売元】
TOKiS/東京電気株式会社
関連商品


New Liver Extract
¥22,000
Unit price perNew Liver Extract
¥22,000
Unit price per

New Japan Natto 360000FU
¥22,000
Unit price perNew Japan Natto 360000FU
¥22,000
Unit price per

Maca 300000
¥22,000
Unit price perMaca 300000
¥22,000
Unit price per